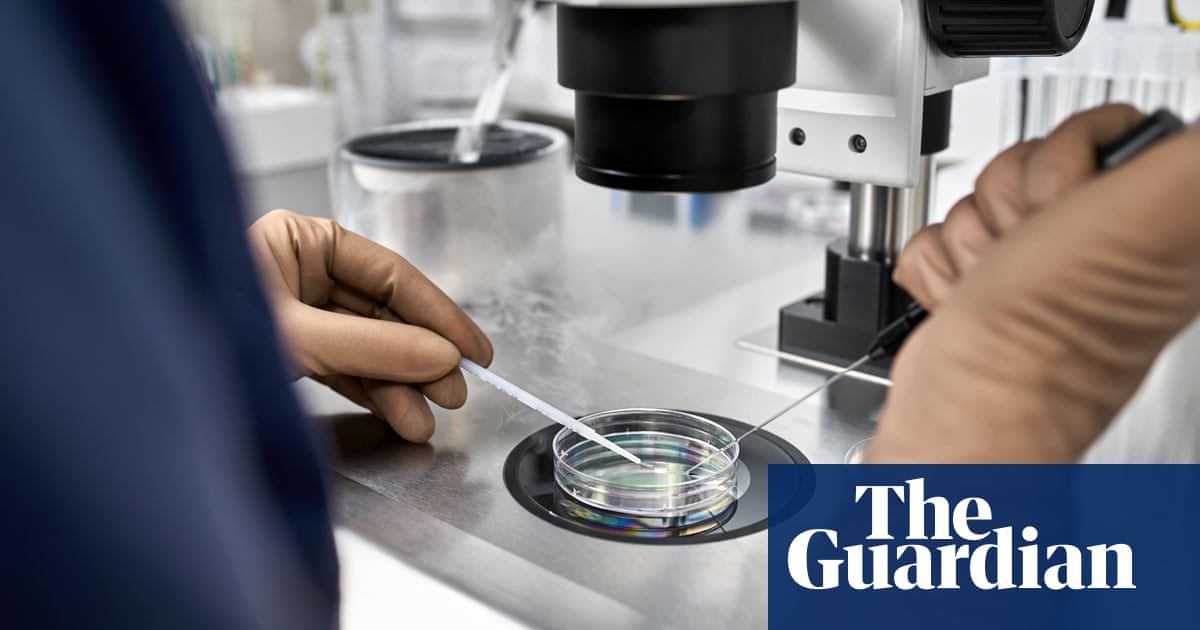

"At least 85 sperm donors in the Netherlands have fathered 25 or more children, revealing long-standing breaches of donation rules by fertility clinics."
"The number of so-called mass donors' should be zero, gynaecologist Marieke Schoonenberg told the TV show Nieuwsuur. We wish to apologise."
"A law aimed at reducing the risk of involuntary incest should have barred donors from fathering more than 25 children since 1992 but was difficult to enforce."
"Data shows at least 85 mass donors in the Netherlands, many fathering between 26 and 40 children, including fertility doctors and prolific donor Jonathan Meijer."
The NVOG reported that over 85 sperm donors in the Netherlands have fathered over 25 children, highlighting significant breaches in sperm donation regulations by fertility clinics. Historically, clinics have reused sperm batches excessively, ignored necessary documentation, and allowed donors to contribute at multiple locations. A law aimed at capping donor offspring to limit incest, established in 1992, was poorly enforced until a new registration system began retroactive application in April. Notably, some donors, including fertility doctors, fathered as many as 81 children, impacting hundreds of families.
Read at www.theguardian.com
Unable to calculate read time
Collection
[
|
...
]